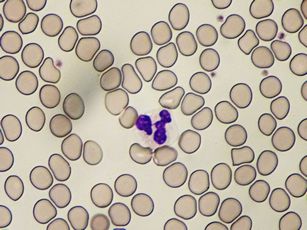

血液検査
血液検査は、貧血、白血病などの血液疾患のほか、さまざまな病気の診断、治療効果の判定、経過観察に欠かせないもっとも基本的な検査のひとつです。

生化学・免疫検査
生化学検査は採血した血液や尿などのさまざまな成分を分析し、からだに異常がないか、どの部分の疾患なのか、炎症があるのか、栄養状態はどうか、などを推測する検査です。

一般検査(尿・便など)
一般検査は、おもに尿と便の検査を指します。その他に、胸水や腹水、脳脊髄液(髄液)、精液などの検査も行っています。
主な検査
- 尿検査 … 尿蛋白、尿糖、潜血反応および尿中細胞成分などの検査を行い、腎機能を調べます。また、糖尿病などの代謝疾患の検査としても重要です。
- 便検査 … 消化管からの出血を調べる潜血反応や、寄生虫の検査があります。

細菌検査
細菌検査室では、細菌や真菌(カビ類)、ウイルスなどの微生物によって起こる感染症を調べる微生物検査を行っています。
微生物検査の内容
微生物検査は、塗抹(顕微鏡)検査、培養・同定検査、薬剤感受性検査からなります。


微生物検査に用いる痰と糞便の採り方
微生物検査では、材料の採り方と保存の仕方によって検査の良否が決まります。
1.喀痰(痰)の採り方と注意点

2.便の採り方と注意点

血液・尿などの検体検査を受けられる方へ
血液・尿検査
血糖や中性脂肪など、食事によって大きな影響を受ける検査項目がありますので、担当医に検査前の食事の可否をご確認ください。
当院で実施した検査について
- 一般的な臨床検査については、当日中に検査結果を担当医に報告しております。
一部の検査については検査終了まで2日~2週間程度必要な項目もありますので、担当医にご確認ください。 - 外来から提出された検査依頼のうち、至急検査については、採血検体到着から1時間以内に依頼科にオンラインで結果報告します。
- 検査結果は、同じ数値であっても、患者さんの病気や服薬いただいている薬物などの診療内容によって医学的な意味が異なります。検査結果については必ず担当医にご確認いただくようお願い申し上げます。
輸血管理
輸血管理室では、安全な輸血を行うための輸血前検査と血液製剤の保管管理のほか、輸血副作用の監視、自己血輸血の推進などを行っています。


